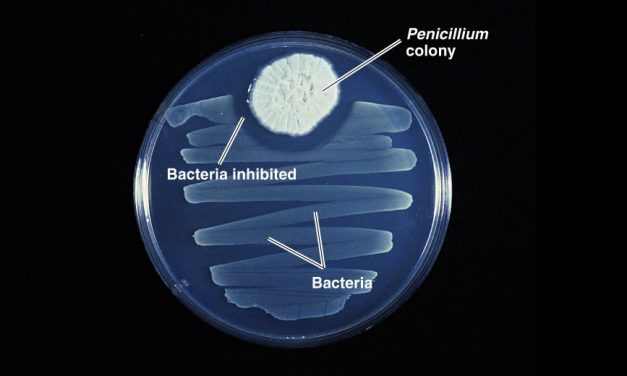
Penicillin – Wonderstuff

Tag: medicine
How Do We Acquire our Own Unique Taste for Foods &...
Mar 29, 2019 | General Interest, Science |
Strange but True : Medical Scanners from Old Battl...
Jul 13, 2018 | General Interest, Science, Technology |
Are Copper or Magnetic Bracelets Effective Against...
May 25, 2018 | General Interest, Trivia |
Why Does Your Whole Body Ache When You Get a Cold ...
Mar 16, 2018 | General Interest, Science |
Bio Sonar Bacteria and Tackling Antibiotic-Resista...
Aug 11, 2017 | Science |
All
LatestWhy Does Alcohol Make You Drunk?
May 30, 2017 | Food & Drink, General Interest |
Alcohol has been used by humans for medicinal and recreational purposes for thousands of years (see the sidebar 'When Was Beer First Brewed'), but scientists still aren't entirely sure how it makes us tipsy
-

How does soap work?
Jun 17, 2016 | General Interest, Science |
-

Great British Inventions
May 20, 2014 | Technology |
-

Great British Inventions
Jan 14, 2014 | Technology |
-

Are We Still Evolving ?
Jan 29, 2013 | Science |
More...
Pontifications – answers to the fluff of everyday life
Oct 16, 2012 |
Answers to some of the amusing questions and fluff we muse on from time to time like : Why are typewriter keys layed out as they are ? ; How exactly does asprin find a headache ? ; Why is the Earth’s core still hot ?
Read MorePenicillin – Wonderstuff
Jun 1, 2012 |
The story of the miracle drug that we tend to take for granted today … Penicillan.
Read More